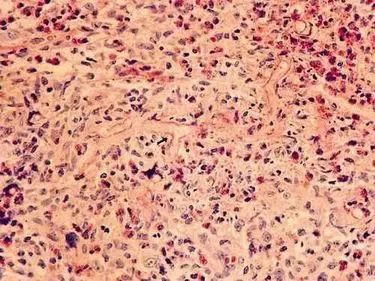

一、毛霉病的元凶
毛霉病的元凶为毛霉目真菌,后者属于毛霉门毛霉纲,大多数为腐生性真菌,分解蛋白的能力较强,为引起食物霉变的常见原因,广泛存在于土壤、粪便等环境中,少数为其他真菌、动植物以及人类的寄生菌。毛霉目真菌通常菌丝发达,呈毛状,因此得名,以无性繁殖为主,形成各种孢子。其中,根霉属、毛霉属和横梗霉属为毛霉病最常见的病原菌,其他致病菌包括根毛霉属、小克银汉霉属、共头霉属、Saksenaea属等。在全球范围内根霉属真菌为最常见的毛霉病病原菌,而地区间又各有其特征,例如亚洲地区近年来鳞质霉属引发的毛霉病病例逐渐增多,我国毛霉病的常见病原体有不规则毛霉、米根霉等。
二、为何会得毛霉病?
毛霉病患者通常具有毛霉目真菌感染的易感因素,包括糖尿病、化疗、应用免疫抑制剂(如肾移植后)、恶性淋巴瘤和其他血液系统肿瘤以及某些自身的基因缺陷(如CARD9基因缺陷)等。由于毛霉目真菌以无性繁殖为主,空气中常有孢子分布,具有易感因素的人群可因吸入空气中的孢子而感染,孢子进入人体后便局部定植。而人体有利于毛霉菌生长的微环境则为其生长和进一步播散提供有利条件。毛霉菌可以利用菌丝直接沿血管侵袭临近部位,也可以利用孢子通过血液循环向周围组织扩散。通常鼻腔、鼻甲、嘴唇、口腔、上颌窦等微循环丰富的软组织为首先受累的部位,随后菌丝进一步蔓延至蝶窦、海绵窦、额窦、颅骨底等部位,从而引起眼部或颅内感染。此外,还有少部分无易感因素的人群也会发生毛霉病,其感染途径主要是各种原因导致的外伤、手术或烧伤,常常引起表现为慢性病程的鼻脑型毛霉病。
毛霉病的发病机制与菌体自身特性和宿主免疫状况密切相关。毛霉目真菌孢子细胞壁上含有的黑色素可通过抑制巨噬细胞功能而获得免疫逃避,此外,孢子在感染部位萌发后亦可诱导免疫细胞凋亡,从而加速疾病进展。毛霉目真菌的毒力与孢子大小有关,孢子越大,毒力越强。另外,菌体自身基因的特殊突变亦会产生对于常规抗真菌药物的耐药性。而宿主自身内环境中丰富的游离铁、高血糖、低血清pH值以及免疫功能低下等则为毛霉病的发生发展提供适宜条件。
三、毛霉病的临床表现
按照感染部位分类,毛霉病可以分为鼻脑型、肺型、胃肠型、皮肤型、播散型等。其中鼻脑型为发生率最高的类型,其次为皮肤型和肺型,总体来说鼻窦炎、肺部疾病和皮肤疾病为毛霉病最常见的临床症状。鼻脑型毛霉病常引起海绵窦综合症、急性眶尖综合症和眼外肌功能障碍,常呈急性病程,临床表现为面部疼痛、头痛、失明、嗜睡,鼻内见褐色、血性微黏稠的分泌物,感染侧腭部有黑色焦痂,真菌易侵犯颅内大血管,引起脑组织梗死等,从而导致患者死亡;皮肤型毛霉病引起的病损为特异性的结节性红斑,红斑周围见苍白圈,红斑进行性增大,局部可坏死,或形成焦痂,或形成溃疡。感染常向深部蔓延,引起局部肌肉与骨骼的病变,也可形成慢性皮肤型毛霉病;肺型毛霉病常表现为肺炎症状,可出现胸痛、咯血、呼吸困难等症状,胸片检查常无诊断意义;胃肠型毛霉病常表现为腹痛、腹胀、发热、胃肠道出血、穿孔等;播散型毛霉病真菌可广泛播散至非、脑、肾、心脏等各种脏器,以肺部最为常见。
四、如何诊断毛霉病
毛霉病的诊断包括影像学、组织病理学、标本直接镜检、培养及菌种鉴定和分子检测等方式。肺部影像学检查通常没有诊断意义,但对于血液系统恶性肿瘤疑似合并肺毛霉病患者,建议用肺部CT检查反晕征(毛玻璃区被高密度环包围的征象),或CT肺动脉造影见血管闭塞。对于疑似鼻脑型毛霉病的患者,建议使用内窥镜或MRI进行检查以进行初步诊断。CT结果对于判断毛霉病病情进展亦有意义;组织病理学检查通常具有一定程度的特征性,急性病变病理可见出血性坏死、血管与神经受累、中性粒细胞浸润,慢性病变中则可见慢性肉芽肿性病变。毛霉菌的宽大无隔或少分隔菌丝和不规则分枝可用于与其他具有分隔透明菌丝的真菌鉴别,另外免疫组化、PCR等技术亦被证明有较高的特异性;菌种鉴定对于临床诊治的意义相对较小,主要用于毛霉病的流行病学研究与指导卫生防控工作,而药敏试验一般只在常规抗真菌药物治疗失败时进行,用于制定新的治疗方案;标本镜检推荐使用荧光染色直接镜检,主要观察菌丝有无分隔、分支角度和菌丝宽度。
五、毛霉病的治疗
毛霉病通常选择抗真菌药物两性霉素B或两性霉素B脂质体进行治疗,疗程常持续数周至数月,抗真菌治疗的同时应尽早对感染部位进行外科手术治疗清除局部病灶。对于存在易感因素的人群,可使用泊沙康唑缓释片进行预防,对于难治性毛霉菌病患者及两性霉素B不能耐受的患者,可选用艾沙康唑进行补救治疗。
六、毛霉病的预防
毛霉病的一级预防包括加强食品、医疗器械的管理避免真菌污染,隔离易感者防止交叉感染,控制糖尿病、白血病、淋巴瘤等基础疾病,控制免疫抑制剂、化疗药物的使用等措施。二级预防主要包括早期诊断和早期治疗。三级预防主要通过使用两性霉素B、联合应用外科手术治疗、控制糖尿病等方式改善预后,降低病死率。此次印度毛霉病的流行,是环境与医疗卫生状况、新冠疫情下类固醇药物的大量使用、患者基础疾病(主要为糖尿病)等多因素共同作用导致。保证两性霉素B等抗真菌药物供应,改善卫生状况,对于医疗器械进行严格消毒,合理使用类固醇类药物以及治疗住院患者基础疾病,对已经确诊的患者进行必要的隔离等措施有助于控制毛霉病的进一步传播。
原标题:《公卫·科普 | 毛霉病知多少》
